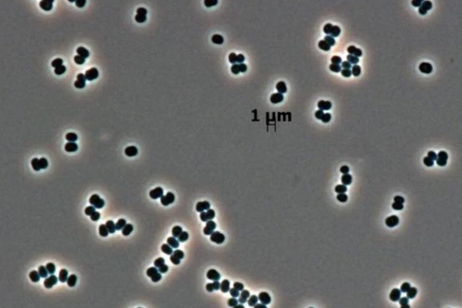
Así es la superbacteria que se infiltró en la NASA y que muy posiblemente hayamos enviado sin querer a Marte

Noticias de ciencia | Últimas noticias y toda la información sobre la actualidad científica
Todas las noticias de ciencia en el mismo lugar. Permanece al tanto de toda la actualidad científica: teorías, noticias, descubrimientos y mucho más.
¿Te apasiona la ciencia? ¿Te intrigan los misterios del universo y los avances que transforman nuestro mundo? Si es así, has llegado al lugar ideal.
Podrás explorar un sinfín de temas. Desde astronomía y astrofísica para descifrar los secretos del universo, hasta los últimos avances en biología, medicina, física y química, medio ambiente o sostenibilidad.
Últimos artículos publicados

El Sol ha lanzado cuatro enormes llamaradas y los científicos están completamente sorprendidos

Encuentran estructuras desconocidas en el campo magnético de la Tierra

Ni trucos de cine ni magia: la ingeniería confirma cómo estos dinosaurios gigantes podían ponerse de pie

La mentira de los 25 años: un estudio masivo revela que tu cerebro sigue siendo "adolescente" hasta los 32

Los científicos de la Universidad de Durham están desconcertados con lo que acaban de encontrar en una estrella moribunda

Tu WiFi se corta con las paredes, este láser no: usan luz ultravioleta invisible para transmitir datos rebotando en la propia atmósfera

La nueva tecnología cuántica que promete resolver el gran misterio del cosmos
Físicos de las universidades de Tokio y Chuo han diseñado un método para localizar la materia oscura sin necesidad de colisiones directas. La propuesta utiliza una red coordinada que mide la velocidad y trayectoria de estas partículas como si fueran ondas cruzando el agua. Es el primer intento serio

Jurassic Park tenía razón (en parte): confirman que los mosquitos son "bibliotecas voladoras" capaces de guardar el ADN de todo un ecosistema
Parece ser que la película de Jurassic Park nos adelantó algo que está siendo descubierto por varios científicos entomólogos. Mucho de su contenido radica en la fantasía y eso está bien pero existe algo importante que no podemos dejar pasar. Una nueva investigación de la Universidad de Florida, repl

Está en el espacio y tiene forma de limón: así es el último descubrimiento del James Webb
[faq pregunta="TEXTO DE LA PREGUNTA"]TEXTO DE LA RESPUESTA[/faq]Un grupo de astrofísicos ha empleado el James Webb para analizar a PSR J2322-2650b, un mundo con aspecto de limón. Este coloso, que iguala la masa del planeta más grande de nuestro sistema, orbita tan pegado a un púlsar que la gravedad

Un grupo de prestigiosos astrofísicos afirma que la materia oscura podría explicar uno de los mayores misterios de nuestra galaxia

Hay una luna en Saturno que lo está cambiando todo: lo que sabíamos sobre ella podría ser falso

Tenía más de 500 años y era el animal más viejo de la Tierra, pero un hombre lo mató sin querer

Descubren un polímero capaz de cambiarlo todo en el espacio: permitiría crear electrónica flexible

El telescopio James Webb acaba de capturar lo que podría ser la primera supernova de la historia

Un grupo de científicos europeos da el primer paso hacia la creación de unas "lentillas inteligentes" capaces de fusionar totalmente el mundo real y el virtual

Investigadores de la Rice University consiguen acabar con los microplásticos de una manera totalmente novedosa

Investigadores del ETH de Zurich descubren un trozo de hielo que podría desbloquear uno de los mayores enigmas de un glaciar

Inquietud y preocupación por la apertura del "mensaje en una botella" que viene de las estrellas

Un satélite de Starlink ha explotado y sus restos van a caer de vuelta a la Tierra
Te puede interesar

Astrónomos de la ESA y la NASA confirman la existencia de 40.000 asteroides que podrían impactar contra la Tierra ¿Deberíamos preocuparnos?

La NASA desmonta uno de los mayores mitos sobre las galaxias y pone en jaque los fundamentos de la astronomía moderna

Estados Unidos acaba de descubrir algo que podría ayudarle a recuperar el control sobre la economía mundial: "Esto lo cambia todo"

Astrónomos de todo el mundo advierten de que esta semana podrás observar una espectacular lluvia de estrellas a simple vista

Hace nueve meses, mandamos a un robot a una de las pocas partes de la Tierra que nunca habíamos visitado, contra todo pronostico, ha sobrevivido al viaje

Tiene el tamaño de un grano de arena, pero lo cambia todo: el 'giro de guion' en la evolución que llega desde Australia

Alerta en la Antártida: detectan cientos de seísmos en el 'Glaciar del Juicio Final' y los científicos ya saben por qué
El glaciar más peligroso del mundo está temblando. Un equipo de científicos ha detectado por primera vez cientos de terremotos en el Thwaites, pero no tienen nada que ver con placas tectónicas. Se trata de seísmos provocados por gigantescos icebergs que, al desprenderse y volcar, golpean el hielo co

Los científicos continúan sin encontrar la última pieza del puzzle nuclear: fracasa un nuevo intento de encontrar a esta partícula fantasma
La búsqueda de una partícula fundamental que complete nuestro entendimiento del universo ha vuelto a fracasar, dos de los experimentos más avanzados de la historia de la física de neutrinos, KATRIN en Alemania y MicroBooNE en Estados Unidos, han publicado de forma independiente sus resultados más pr

¿Te da rabia despertarte 5 minutos antes de la alarma? Los expertos explican por qué en realidad es una gran noticia para tu salud
Despertarse justo antes de que suene el despertador no es una maldición, sino la prueba definitiva de que tu reloj biológico funciona con la precisión de un suizo. Según explican los expertos en ScienceAlert, este fenómeno indica que tu cuerpo ha aprendido a sincronizar sus ritmos circadianos con tu

Lo que los geólogos han encontrado en el fondo del mar que apunta directamente a Marte: una conexión imposible de ignorar

El arma de fuego más antigua de Estados Unidos es española

La pieza que faltaba para frenar el cambio climático es minúscula: por qué un simple aditivo ha puesto en alerta a la comunidad científica

Astrónomos "cazan" a una agrupación gigante de galaxias realizando un extraño movimiento al unísono

Un nuevo mapa fluvial de Marte sugiere la existencia de extensas zonas habitables en el planeta rojo y resuelve un misterio centenario

El superordenador más potente del mundo simula lo que pasaría si te cayeses dentro de un agujero negro

Acabamos de dar un paso de gigante en la física cuántica: científicos inventan un procesador 100 veces más potente que el más avanzado hasta ahora

Muy atento al cielo esta noche: podrás observar sin necesidad de telescopio un extraño fenómeno astronómico
Así es la superbacteria que se infiltró en la NASA y que muy posiblemente hayamos enviado sin querer a Marte

Llevaba 9.000 años en silencio, pero ahora ha entrado en erupción y está convirtiendo el tráfico aéreo en un auténtico caos

Adiós a la minería tóxica: el revolucionario 'virus de diseño' que extrae el tesoro más valioso del planeta y amenaza el monopolio chino

Olvídate de los SSD, lo que se lleva ahora en el mundo de los discos duros es almacenar tus datos en ADN sintético

Se convirtió en un yermo nuclear en los años 80, pero ahora la vida se abre camino de las maneras más impresionantes en él

Europa encuentra una alternativa limpia para reducir el impacto ecológico de la IA: el primer reactor nuclear de neutrones rápidos del mundo

Un crimen llevaba siglos sin resolverse, pero gracias a una técnica futurista finalmente se ha llegado a una conclusión

Es el 85% del universo y nadie la había visto antes: aseguran haber detectado materia oscura por primera vez gracias a un telescopio de la NASA

Nuevo hito para la ciencia: astrónomos de Tokio han logrado ver materia oscura por primera vez en la historia
La materia oscura, uno de los objetos más misteriosos del Universo del que solo conocemos su existencia por las ondas gravitacionales que genera, se había caracterizado por ser prácticamente indetectable para las tecnologías de observación, debido a que la materia oscura no emite luz, ni la refleja.

Japón irrumpe en la carrera hacia la energía infinita con un diseño compacto que está "a las puertas de ser implementado"
En un avance significativo para lograr la generación de energía a través de la fusión nuclear, el proyecto japonés FAST (Fusion by Advanced Superconducting Tokamak) ha completado su diseño conceptual apenas un año después de su lanzamiento, un logro anunciado por Starlight Engine y Kyoto Fusioneerin

Unos científicos encontraron restos de un asteroide, al estudiarlos descubrieron pruebas que confirman el origen de la vida en la tierra
Científicos de la NASA han confirmado el hallazgo de triptófano, uno de los aminoácidos más complejos y esenciales para la vida en la tierra, en muestras del asteroide Bennu, este descubrimiento se ha materializado gracias a la misión OSIRIS-REx, que trajo 121,6 gramos de material del asteroide a la

Unos científicos encontraron una piedra lunar. Decidieron romperla y lo que encontraron en su interior les dejó boquiabiertos

Por primera vez, la NASA ha capturado algo que no se había visto en Marte. El crepitar de un trueno

Tras siglos de especulaciones y teorías falsas, por fin sabemos algo sobre el objeto del tamaño de Marte que se estrelló contra la tierra

La amenaza silenciosa para el planeta Tierra yace bajo nuestros pies y tiene un poder devastador

Avi Loeb, científico de Harvard, está seguro: pronto podríamos encontrar vida extraterrestre

Estamos a punto de resolver uno de los mayores misterios de la biología: crean un "cerebro artificial" que les permite observar a la célula más misteriosa y abundante de nuestro cuerpo

De chimpancés a neandertales: un análisis evolutivo destapa que los primeros Homo sapiens besaban a otras especies

Las cotorras no eligen amigos al azar: un estudio revela que "tantean el terreno" con una táctica casi humana

La Voyager 1 roza una frontera aterradora: pronto se convertirá en el primer objeto humano a un 'día luz' de casa

Avi Loeb, experto de Harvard sobre vida extraterrestre, advierte que el 3I/ATLAS podría estar diseñado para colonizar Júpiter: "parece que la tierra no le interesa"

El disco que aguarda en Marte: el último y sobrecogedor mensaje de Carl Sagan a la humanidad

Científicos descubren al 'superdepredador' marino que devoraba orcas y competía con el megalodón

Una indigestión prehistórica facilita la identificación de una especie extinta completamente desconocida hasta la fecha

Los científicos se habían equivocado: el Sistema Solar se mueve mucho más deprisa de lo que se estimaba

Así es como el estrés impacta tu cerebro: la conexión clave descubierta que afecta el aprendizaje y la adicción

Aunque muchos países han reducido sus emisiones, la concentración global de CO2 está en máximos históricos

Los arqueólogos llevan décadas descubriendo calaveras humanas con el mismo agujero, ahora sabemos como era la herramienta que usaban para hacerlos
Durante más de un siglo, arqueólogos de todo el mundo han desenterrado cráneos humanos con una característica común; un orificio circular perfectamente ejecutado en el hueso craneal, estos agujeros, presentes en restos que abarcan desde los comienzos de la civilización humana hasta la Edad Media, er

Se resuelve un problema que existe desde el primer astronauta: acaban de encontrar vida capaz de resistir en el espacio, y siempre estuvo en la Tierra
La NASA tiene finalmente respuesta a una pregunta que ha perseguido a los científicos espaciales desde los primeros días de la exploración orbital: ¿qué formas de vida terrestres pueden sobrevivir en el vacío del espacio? La respuesta, según un estudio publicado en iScience, nace de unas estructuras

La NASA revela, por fin, la primera fotografía de 3I/ATLAS
Por fin. Tras semanas de silencio forzado, parálisis burocrática y una polémica absurdamente mediática sobre si estábamos o no ante una nave alienígena, la NASA ha cumplido su palabra. El objeto 3I/ATLAS, el visitante interestelar que el mes pasado hizo un flyby espectacular por Marte, ya tiene su p

Desarrollan un modelo de inteligencia artificial que previene la metástasis de uno de los cánceres más comunes

El 'Santo Grial' de la astrofísica ya es real: la IA que recrea la Vía Láctea estrella por estrella por primera vez

Giro de 180 grados en la astronomía: la explosión de las estrellas no es como nos la habían contado

Adiós a la cirugía cerebral: los 'nanobots' híbridos del MIT que viajan por tus venas para reparar el cerebro

Adiós a los beneficios de tu dieta: el gesto cotidiano que los anula por completo

Se ha encontrado la telaraña más grande del mundo, y se encuentra más cerca de lo que imaginas

La NASA podría precipitar un asteroide contra la Luna por accidente

Se lo debemos todo a Júpiter. Su existencia salvó a la Tierra de la extinción

El agujero negro que ha "deslumbrado" al mundo de la astronomía. Ha emitido una llamarada con la potencia de 10 billones de soles

El 3I/ATLAS se rompe cerca del Sol generando una gran controversia: los científicos están realmente confusos

Un equipo científico formado por reputados físicos demuestran que es imposible que vivamos en una simulación

El 3I/ATLAS bombardea la Tierra con una extraña señal de radio, pero su origen es controvertido

El secreto de los 70 años: científicos resuelven el misterio del calor "imposible" del Sol

Avi Loeb, experto en vida extraterrestre de Harvard, sobre el 3I/ATLAS: "Si es inteligente, estamos en problemas"

El cometa 3I/ATLAS será visible este noviembre: estos son los lugares y las fechas en las que podrás verlo

Elon Musk, CEO de SpaceX, sobre el cambio climático: “Hay quienes dicen que no existe y quienes afirman que el mundo estará bajo el agua en cinco años, pero la realidad es otra"

Un meteorito impactó en China hace 10.000 años, y su fuerza fue equivalente a la de 40 bombas atómicas
El cráter de Yilan, bien conocido en el territorio chino por su gran tamaño y las numerosas teorías a su alrededor, ha sido investigado por un equipo de científicos y se ha llevado a cabo un llamativo descubrimiento sobre su origen. Tras analizar su composición geológica, se estima que el impacto tu

Aunque parezca imposible, el agua derretida de la Antártida nos está protegiendo del CO2, según un estudio
El agua procedente del hielo que se derrite en la Antártida, según un nuevo estudio, está siendo consecuencia y a la vez un leve freno contra el cambio climático. Este fenómeno, producido por la actividad humana que ha disparado la proporción de dióxido de carbono en la atmósfera y ha incrementado e

El controvertido astrónomo Avi Loeb cree que un misterioso objeto oculto tras el Sol podría ser una nave alienígena
El objeto interestelar 3I/ATLAS llegará el 29 de octubre a su perihelio, el punto más cercano al Sol. Esta semana alcanzó su conjunción solar, situándose justo al otro lado del Sol desde la Tierra. La comunidad científica tiene pruebas de que se trata de un cometa de hielo de dióxido de carbono, per

¿Qué está pasando con NASA y SpaceX en su misión a la Luna?

Un agujero negro habría "devorado" una estrella de mayor tamaño después de caer en ella. La ciencia sigue impactada ante tal suceso

Unos extraños surcos encontrados en Marte han reavivado teorías sobre la vida y el agua de este planeta. Tiene una explicación mucho más sencilla

El mortal desafío de llegar a Marte: huesos disueltos, corazón encogido y fluidos en el cerebro. Los astronautas aún no están preparados

Las corrientes de los planetas gaseosos al descubierto: un nuevo estudio revela por qué sus "chorros" podían girar en direcciones opuestas

El "Google para el ADN" es real: científicos crean un buscador que rastrea todo el código genético del planeta en segundos

Tiene 9.000 años y su especie se extinguió hace milenios, pero está tan bien conservado que quieren resucitarlo

La misteriosa agua de Encélado: una de las lunas de Saturno tiene posibles indicios de vida en sus océanos

Residuos nucleares reciclados: la NASA usará baterías con americio 241 para los róveres enviados a Marte o la Luna
